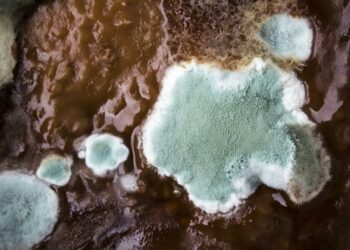
Pourquoi mon terrarium moisi ?

Guide Animaux
Guides sur les animaux de compagnie, chiens, chats et rongeurs : comment choisir, éduquer, comprendre, nourrir, soigner son animal. Découvrez nos conseils et astuces pour bien prendre soin de votre animal.
Comment se débarrasser de la gale remède de Grand-mère ?
Pour vous débarrasser de la gale , prenez votre flacon vide, et ajoutez : 10 gouttes d'huile essentielle de Lavande...
Pourquoi mes canaris ne s’accouplent pas ?
Il faut que vos oiseaux aient au moins un an pour avoir un accouplement valable ---De plus vérifier s'il s'agit...
Qu’est-ce que les lapins adorent ?
Le lapin aime être caressé dans le sens du poil, se faire gratter le dos, les joues et la base...
Est-ce que les lapins craignent la pluie ?
et attention également au vent, les lapins ne craignent pas la pluie (leur pelage est étanche), mais le vent peut...
Comment sont les plumes ?
Les sortes de plumes Certaines plumes, comme les plumes de vol et celles de la queue, sont solides et raides...
Pourquoi mettre un chien dans une cage ?
Avantages à utiliser la cage correctement Accélération de l'apprentissage de la propreté chez un chiot (ou un chien adulte) Sentiment...
Quel est le poulailler idéal ?
Paradoxalement, un bon poulailler se doit d'être à la fois exempt de courant d'air, mais bien aéré En général, les...
Pourquoi mon terrarium moisi ?
Les moisissures sont le signe d'une humidité trop élevée dans votre terrarium Ôtez les parties atteintes et laissez le contenant...
Comment arrêter deux chiens qui se battent ?
Idéalement, éviter le combat Vous pouvez empêcher votre compagnon de se battre en détournant son attention Interdisez-lui de s'approcher de...
Est-ce que les hamsters aiment les caresses ?
Caressez-le toujours en douceur, dans le sens du poil et laissez-lui bien le temps de vous sentir quand il en...